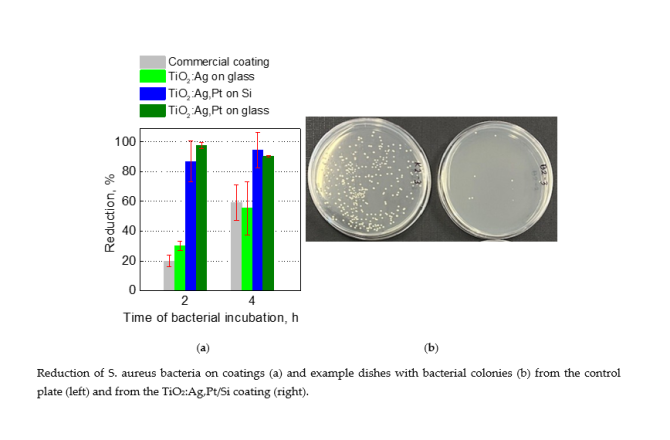

News

Young Researchers from the University of Rzeszów Establish Local Branch of the FEBS Junior Section Poland
The primary goal of FEBS Junior Poland is to foster collaboration and shared initiatives, including thematic discussions, scientific conferences, symposia, and workshops





Participation of Prof Idalia Kasprzyk in the 4th Interregional Learning Workshop of the GRENHEALTH Project in Sweden
Participation of Prof Idalia Kasprzyk in the 4th Interregional Learning Workshop of the GRENHEALTH Project in Sweden

Highly Effective Antibacterial Coating for Use in Protective Glass Applications on Smartphone and Smartwatch Touchscreens
The University of Rzeszów and ML System invite companies interested in implementing this coating for industrial-scale production




University of Rzeszów to Prepare Environmental Documentation for 13 Protected Landscape Areas in Subcarpathia
The project is led by Prof. Krzysztof Kukuła, an expert in ecology, environmental protection, and nature conservation



Education and Nature Protection: University of Rzeszów and the Landscape Parks Complex in Przemyśl Join Forces
The document outlines the principles of joint initiatives within the framework of the project “Excellent Podkarpacie – Comprehensive Environmental Research at the University of Rzeszów for the Benefit of the Region,” implemented under the “Regional Initiative of Excellence” program



Agreement Between the University of Rzeszów and Nowa Sarzyna. The Pontic Azalea in the Spotlight
The partnership will focus on joint initiatives, including educational and promotional projects aimed at the protection of biodiversity—particularly in the Kołacznia Nature Reserve, home to the Pontic azalea (Rhododendron luteum), also known as the yellow azalea










